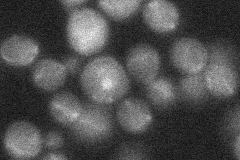
YKR056W

View description
tRNA methyltransferase, 5-methylates the uridine residue at position 54 of tRNAs and may also have a role in tRNA stabilization or maturation; endo-exonuclease with a role in DNA repair
Localization:
Intensity:
Fold change:
Significance:
-
C’ GFP library in SD

cytosol19.05 -
N' NOP1pr-GFP in SD

ER,punctate43.9368 -
N' TEF2pr-mCherry in SD

ER26.5832 -
N' NATIVEpr-GFP in SD
below threshold19.1603 -
N' TEF2pr-VC and Cyto-VN in SD

#N/A0 -
C’ GFP library in SD+DTT

cytosol16.50.86No -
C’ GFP library in SD+H2O2

cytosol18.040.94No -
C’ GFP library in Starvation Media

cytosol14.710.77No -
C’ GFP library on the background of Pup2-DaMP

cytosol -
C’ GFP library on the background of CCT mutant

cytosol21.06651.10513No
